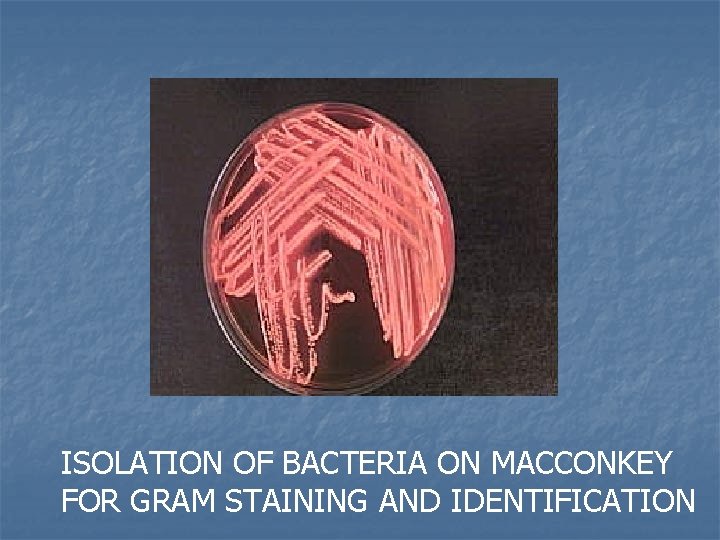

ISOLATION GRAM STAINING AND IDENTIFICATION OF BACTERIA BY

ISOLATION, GRAM STAINING AND IDENTIFICATION OF BACTERIA BY DR. TED PASS II KENTUCKY MICROBIOLOGY LABORATORY CERTIFICATION PROGRAM

PROCEDURE FOLLOWED TO IDENTIFY BACTERIA n n n OBTAIN A PURE CULTURE USING A DIFFERENTIAL MEDIA SUCH AS MACCONKEY AGAR PREPARE A SLIDE USING GRAM STAIN PROCEDURE IDENTIFY BACTERILA ISOLATES USING THE API OR ENTEROTUBE IDENTIFICATION SYSTEM

MACCONKEY AGAR Mac. Conkey agar is probably the most popular solid differential/selective medium in the world. It is mainly used in isolation of lactose fermenting, Gram-negative enteric pathogens and for inhibiting growth of Gram-positive organisms. Bacterial colonies that can ferment lactose turn the medium red. This red color is due to the p. H indicators (Neutral Red) response to the acidic environment created by the fermentation of lactose. MAC is decolorized by NLF bacteria. . . as they utilize Amino Acids alkaline metabolites are released and the Neutral Red becomes colorless.

Lactose Fermentors vs Non Lactose Fermentors n Examples of LF: Escherichia coli Klebsiella pneumoniae Enterobacter aerogenes Citrobacter freundi Examples of NLF: Pseudomonas aeruginosa Proteus mirabilis *Gram Positive bacteria are inhibited by Crystal violet and bile salts…i. e. , Staphylococcus aureus

ISOLATION STREAK TECHNIQUE
ISOLATION OF BACTERIA ON MACCONKEY FOR GRAM STAINING AND IDENTIFICATION

Gram-Staining Procedure The reagents you will need to successfully perform this technique are: • Crystal Violet ( Primary Stain) • Iodine Solution (Mordant) • Decolorizer ( 95%Ethanol ) • Safranin ( Counterstain) • Water (preferably in a squirt bottle)

SMEAR PREPARATION STEP 1 STEP 3 STEP 2 STEP 4

STAINING PROCEDURE n STEP 1: Flood (cover completely) the entire slide with Crystal Violet…CV attaches to the cell wall of both G+ and Gbacteria. Let the crystal violet stand for about 60 seconds.

STEP 2: Now, flood your slide with the iodine solution. n Rinse the slide with water after 60 sec. At this point, the specimen should appear brownish to blue-violet in color. Iodine strengthens the bond between the CW and the CV

STEP 3: Add the Decolorizer, Ethanol for 15 sec. n To be safe, add the Ethanol dropwise until the blue-violet color is no longer emitted from your specimen…Removes 20% lipids, i. e. , LPS and CV-I complex (Decolorizing the cell) Quickly, rinse the slide with the water for 5 seconds.

STEP 4: The final step involves applying the Counterstain, Safranin. n Flood the slide with the dye as you did in steps 1 and 2. Let this stand for about a 60 sec. Rinse with water for 5 seconds to remove any excess dye. Safranin will attach to G- Cell Wall


GRAM NEGATIVE AND GRAM POSITIVE ORGANISMS

GRAM POSITIVE COCCI

GRAM NEGATIVE RODS GRAM POSITIVE COCCI

The Gram stain differentiates between bacteria that possess 2% and 20% Lipids in their cell wall or "cell envelope“. The G- CW has an outer membrane of Lipopolysaccharides LPS)

ENDOSPORE SLIDE

API IDENTIFICATION SYSTEM n This API-20 E test strip (from bio. Merieux, Inc. ) is used to identify the enteric gram negative rods; 20 separate test compartments are on the strip, all dehydrated. A bacterial suspension is used to rehydrate each of the wells. Some of the wells will have color changes due to p. H differences: others produce end products that have to be identified with reagents. A profile number is determined from the sequence of + and - test results, then looked up in a codebook having a correlation between numbers and bacterial species.

INOCULATION OF AN API STRIP n n n Prepare a suspension of the bacteria in the saline tube Inoculate a large colony (2 -3 mm diameter)of the bacterium (pure culture) into the 0. 85% Na. Cl solution. Use a Mc. Farland barium sulfate standard #3

INOCULATION n n Holding the strip at a slight angle up from the table top, you will now inoculate the bacterial suspension into each well with the sterile pipette. Touch the end of the pipette to the side of the cupule, allowing capillary action to draw the fluid into the well as you slowly squeeze the bulb. This should eliminate any bubbles forming in the wells. Each well should be filled up to the neck (see diagram). CIT, VP, and GEL have boxes around their names. These test wells will be filled all the way up to the top of the well. LDC, ODC, ADH, H 2 S, and URE are filled as described in step B, but they will then be filled up to the top with sterile mineral oil.

TILT AT ANGLE TO FILL CUPULES

Incubate the strip in its chamber n n The bottom of the incubation chamber has small indented wells in the bottom: fill it with water just enough to fill these indentations. Place the strip into this bottom. There should not be so much water that it spills onto the API strip. Place the top of the incubation chamber over the bottom, and label it. Place the strip at 35 to 37º C for 18 -24 hours.

• n n n INTERPRETATION: Add the proper reagents to the compartments: 1 drop of Kovac's to the IND (read within a couple of minutes) 1 drop of Barritt's A and B to VP (a positive reaction may take up to 10 minutes) 1 drop of Fe. Cl 3 to TDA

n n Record results on the diagram handed out to you in lab (1, 2, or 4 points for + reaction, 0 points for - reaction). The oxidase test reaction should be negative, and is added as the last test result. Three test reactions are added together at a time to give a 7 -digit number, which can then be looked up in the codebook.

ENTEROTUBE IDENTIFICATION SYSTEM n The Enterotube® II contains 12 different agars enabling the performance of a total of 15 biochemical tests as well as an enclosed inoculating wire.

ENTEROTUBE INOCULATION

INOCULATION OF ENTEROTUBE n n 1. Remove both caps of the Enterotube® II and with the straight end of the inoculating wire, pick off the equivalent of a colony from your unknown plate. A visible inoculum should be seen on the tip and side of the wire. 2. Inoculate the Enterotube® II by grasping the bent-end of the inoculating wire, twisting it, and withdrawing the wire through all 12 compartments using a turning motion.

ENTEROTUBE (contd. ) n 3. Reinsert the wire into the tube (use a turning motion) through all 12 compartments until the notch on the wire is aligned with the opening of the tube. (The tip of the wire should be seen in the citrate compartment. ) Break the wire at the notch by bending. Do not discard the wire yet.

ENTEROTUBE (contd. ) n n 4. Using the broken off part of the wire, punch holes through the cellophane which covers the air inlets located on the rounded side of the last 8 compartments. Your instructor will show you their correct location. Discard the broken off wire in the SHARPS container. 5. Replace both caps and incubate the Enterotube® II on its flat surface at 3537°C. for 18 -24 hours.



POSITIVE REACTIONS
- Slides: 33